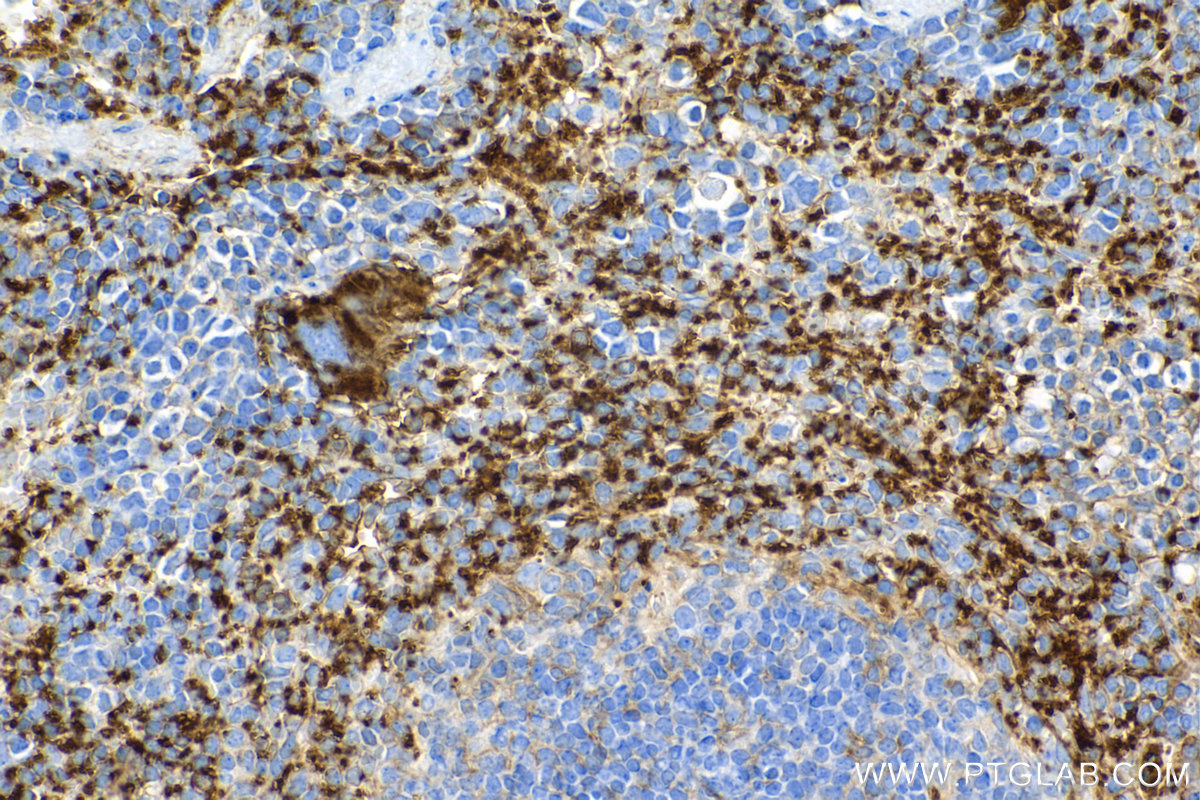
IHC staining of mouse spleen using 84801-13-RR
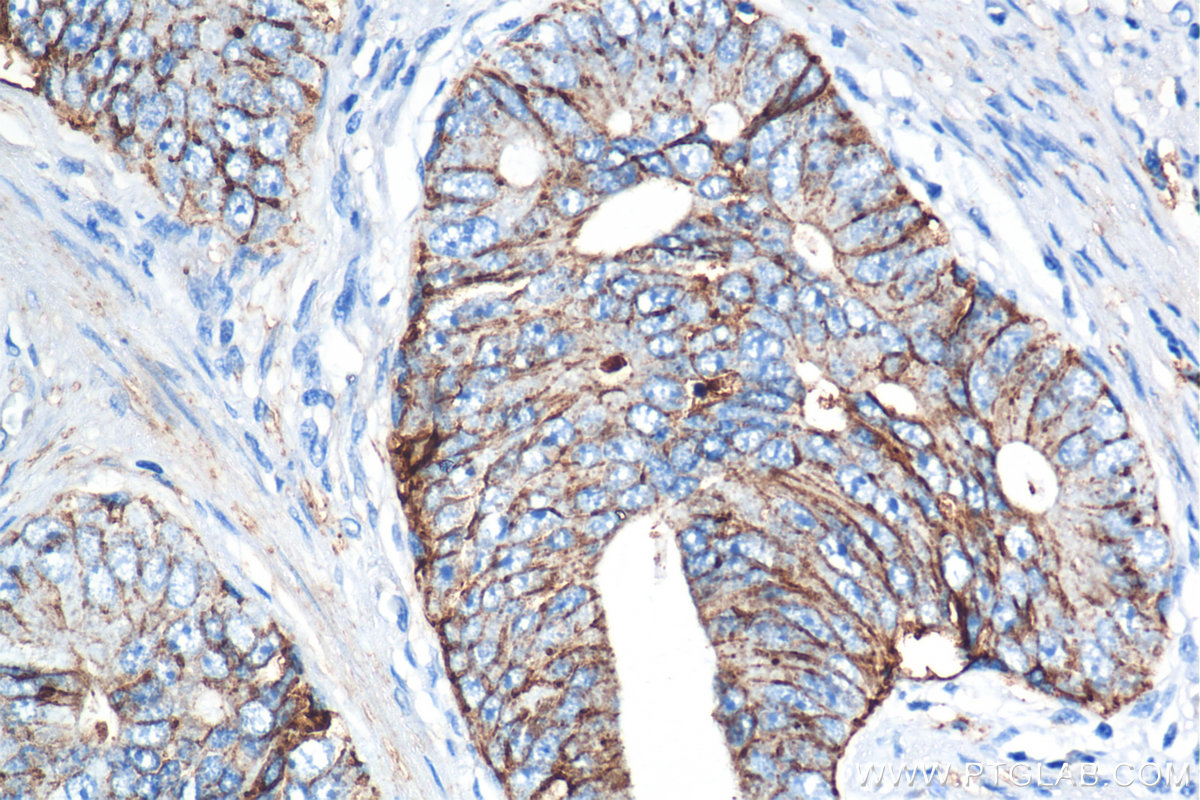
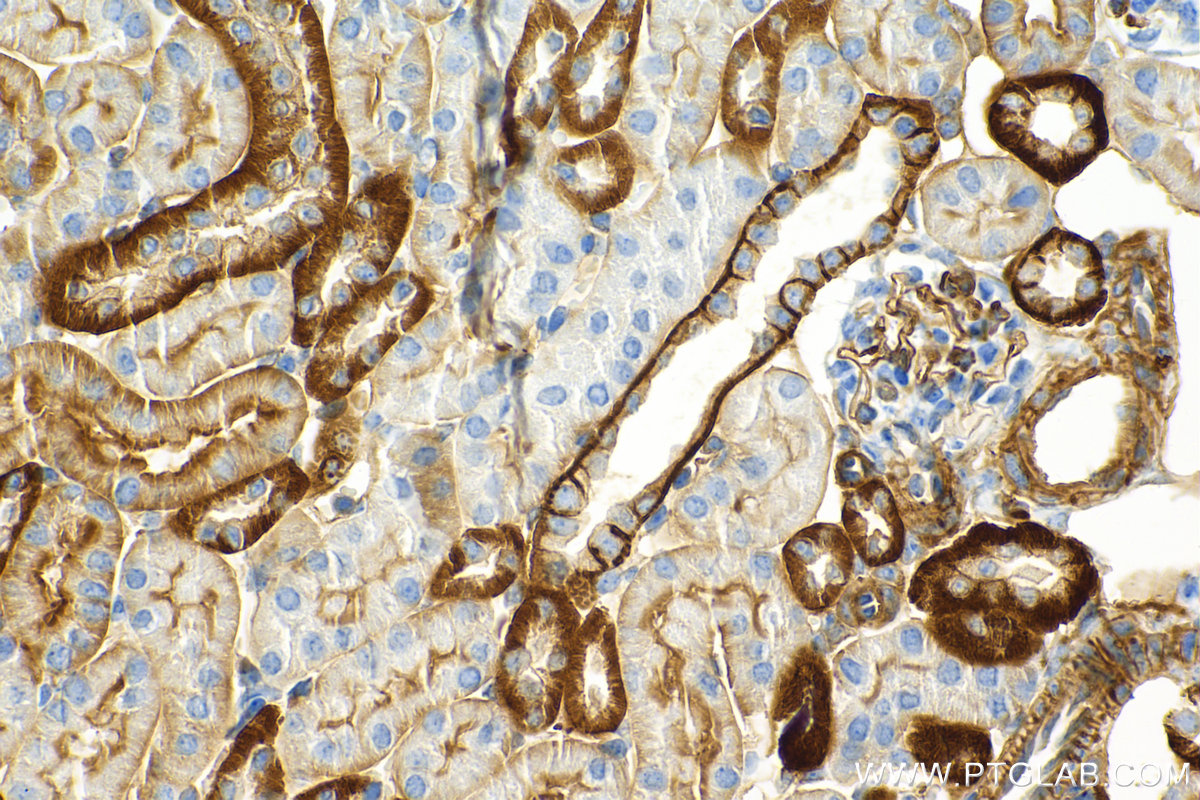

验证数据展示
经过测试的应用
| Positive WB detected in | RAW 264.7 cells, J774A.1 cells, mouse spleen tissue |
| Positive IHC detected in | mouse spleen tissue, human prostate cancer tissue, mouse kidney tissue, rat spleen tissue Note: suggested antigen retrieval with TE buffer pH 9.0; (*) Alternatively, antigen retrieval may be performed with citrate buffer pH 6.0 |
| Positive IF-P detected in | mouse spleen tissue |
推荐稀释比
| 应用 | 推荐稀释比 |
|---|---|
| Western Blot (WB) | WB : 1:500-1:2000 |
| Immunohistochemistry (IHC) | IHC : 1:1000-1:4000 |
| Immunofluorescence (IF)-P | IF-P : 1:250-1:1000 |
| It is recommended that this reagent should be titrated in each testing system to obtain optimal results. | |
| Sample-dependent, Check data in validation data gallery. | |
发表文章中的应用
| WB | See 7 publications below |
产品信息
84801-13-RR targets CD9 in WB, IHC, IF-P, ELISA applications and shows reactivity with human, mouse, rat samples.
| 经测试应用 | WB, IHC, IF-P, ELISA Application Description |
| 文献引用应用 | WB |
| 经测试反应性 | human, mouse, rat |
| 文献引用反应性 | human, mouse, rat |
| 免疫原 |
CatNo: Eg1397 Product name: Recombinant Mouse CD9 protein (rFc Tag) Source: mammalian cells-derived, pHZ-KIsec-C-rFc Tag: C-rFc Domain: 110-193 aa of NM_007657.3 Sequence: THKDEVIKELQEFYKDTYQKLRSKDEPQRETLKAIHMALDCCGIAGPLEQFISDTCPKKQLLESFQVKPCPEAISEVFNNKFHI 种属同源性预测 |
| 宿主/亚型 | Rabbit / IgG |
| 抗体类别 | Recombinant |
| 产品类型 | Antibody |
| 全称 | CD9 antigen |
| 别名 | CD9 antigen, MIC3, P24, Tspan 29, TSPAN29 |
| 计算分子量 | 25 kDa |
| 观测分子量 | 23 kDa |
| GenBank蛋白编号 | NM_007657.3 |
| 基因名称 | Cd9 |
| Gene ID (NCBI) | 12527 |
| RRID | AB_3743746 |
| 偶联类型 | Unconjugated |
| 形式 | Liquid |
| 纯化方式 | Protein A purification |
| UNIPROT ID | P40240 |
| 储存缓冲液 | PBS with 0.02% sodium azide and 50% glycerol, pH 7.3. |
| 储存条件 | Store at -20°C. Stable for one year after shipment. Aliquoting is unnecessary for -20oC storage. |
背景介绍
CD9, also known as Tspan-29, p24, or MIC3, is a member of the tetraspanin superfamily (PMID: 1879540). It is expressed on a large variety of hematopoietic and non-hematopoietic cells, such as stromal cells, megakaryocytes, platelets, B and T lymphocytes, dendritic cells, endothelial cells, mast cells, eosinophils, and basophils (PMID: 30356731). CD9 interacts with the integrin family and other membrane proteins, and is involved in cell adhesion, cell motility, and tumor metastasis (PMID: 8478605; 21428940; 25805926). Expression of CD9 enhances membrane fusion between muscle cells and supports myotube maintenance (PMID:10459022). On oocytes, CD9 is hypothesized to play a role in the fertilization of mammals (PMID: 25536312).
实验方案
| Product Specific Protocols | |
|---|---|
| IF protocol for CD9 antibody 84801-13-RR | Download protocol |
| IHC protocol for CD9 antibody 84801-13-RR | Download protocol |
| WB protocol for CD9 antibody 84801-13-RR | Download protocol |
| Standard Protocols | |
|---|---|
| Click here to view our Standard Protocols |
发表文章
| Species | Application | Title |
|---|---|---|
Biomed Mater Low-intensity pulsed ultrasound as a strategy to boost exosome secretion by adipose-derived stem cells and uptake for myocardial infarction therapy | ||
ACS Appl Mater Interfaces A Dual-Factor Scaffold for Spinal Cord Injury Repair Targeting Inflammation and Ferroptosis | ||
Regen Biomater Injectable exosome-reinforced konjac glucomannan composite hydrogel for repairing cartilage defect: activation of endogenous antioxidant pathways. | ||
Int J Mol Med Targeting of CIRP attenuates osteoarthritis progression via suppressing TLR4/NF‑κB/NLRP3 signaling axis. | ||
J Orthop Surg Res Exosomal miR-223-3p from mesenchymal stem cells targets FBXW7 to inhibit intervertebral disc degeneration: mechanism insights. | ||
Acta Pharm Sin B Extracellular vesicles-derived hybrid biomimetic nanoplatforms camouflaged Golgi apparatus-targeted aggregation induced emission photosensitizer to elicit pyroptosis and immunogenic cell death for efficient antitumor photoimmunotherapy. |